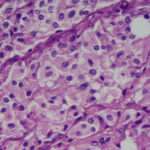
Feocromocitoma y Paraganglioma

El páncreas es un órgano ubicado detrás del estómago y tiene funciones tanto endocrinas como exocrinas. Su función endocrina implica la producción y liberación de hormonas, siendo la insulina y el glucagón las más importantes para regular los niveles de glucosa en sangre.
En la función exocrina, el páncreas produce enzimas digestivas que se liberan en el intestino delgado para ayudar en la digestión de los alimentos. Estas enzimas son esenciales para descomponer proteínas, grasas y carbohidratos, permitiendo la absorción de nutrientes en el sistema digestivo.
La insulina es crucial para el metabolismo de los carbohidratos y la regulación del azúcar en la sangre. Cuando los niveles de glucosa aumentan después de comer, la insulina ayuda a que las células absorban la glucosa, disminuyendo así su concentración en la sangre. Por otro lado, el glucagón eleva los niveles de glucosa en la sangre cuando estos son bajos, desencadenando la liberación de glucosa almacenada en el hígado.
Configuración anatómica externa del páncreas
El páncreas, una glándula alargada que se extiende de derecha a izquierda y de abajo hacia arriba, presenta una configuración aplanada en sentido anteroposterior. Su morfología se compone de cuatro partes principales: cabeza, cuello, cuerpo y cola. La cabeza, ubicada en el lado derecho, se sitúa cerca del duodeno, la primera porción del intestino delgado, manteniendo proximidad con la vesícula biliar. El cuello, región estrecha, conecta la cabeza con el cuerpo del órgano. El cuerpo, la parte más extensa, se extiende hacia la izquierda desde el cuello, ocupando una posición posterior en la cavidad abdominal. La cola, la sección más delgada, proyecta hacia arriba y a la izquierda, y se encuentra en contacto con el bazo, otro órgano del sistema linfático.
Esta estructura glandular exhibe una concavidad posterior que se adapta a la columna lumbar, específicamente a nivel de las vértebras L1-L2. Esta relación anatómica es de importancia fundamental para la ubicación y función del páncreas en el complejo entramado abdominal.
Cabeza
La cabeza del páncreas se posiciona de manera particular, inclinándose ligeramente hacia adelante y a la derecha, y está delimitada por la presencia cercana del duodeno, la primera porción del intestino delgado. Un detalle distintivo en su anatomía es la existencia de un canal ahuecado en su borde superior y derecho, un canal que sirve de soporte al duodeno y que, en la descripción de Gregoire, evoca la imagen de un «neumático en su llanta».
Este canal, sin embargo, desaparece en el borde inferior de la cabeza, donde esta región del páncreas entra en contacto directo con la porción horizontal del duodeno, evidenciando una conexión continua entre ambos elementos anatómicos. Descendiendo hacia abajo y curvándose hacia la izquierda, la cabeza adopta una forma de gancho, constituyendo lo que se conoce como el proceso unciforme o páncreas menor de Winslow.
Este proceso unciforme se extiende por detrás de los vasos mesentéricos superiores, siguiendo el borde superior de las porciones horizontal y ascendente del duodeno. En su cara anterior, presenta una peculiar excavación en forma de canal, diseñada para permitir el paso de la vena mesentérica superior, evidenciando una adaptación anatómica precisa para facilitar la circulación sanguínea en esa región específica.
Así, estos detalles anatómicos específicos ofrecen una visión más detallada de la morfología y la posición de la cabeza del páncreas, destacando su relación intrincada con el duodeno y su interacción con importantes estructuras vasculares en el complejo entorno abdominal.
Cuello
El cuello, también conocido como istmo del páncreas, es la porción que establece la conexión anatómica entre la cabeza y el cuerpo del páncreas. Esta región, de aproximadamente dos centímetros de longitud, presenta características particulares que revelan su posición y relación con estructuras circundantes.
En su límite superior, el cuello se encuentra en contacto con la porción superior del duodeno, la primera parte del intestino delgado. En esta zona, se destacan dos tubérculos en el borde superior del cuello. El tubérculo anterior se sitúa debajo del duodeno y, en ocasiones, puede confundirse con la parte superior de la cabeza del páncreas. Por otro lado, el tubérculo posterior, conocido como tubérculo omental o epiploico, se encuentra ubicado detrás del duodeno, en la unión entre el cuello y el cuerpo del páncreas.
Hacia la parte inferior, el cuello está limitado por la incisura pancreática. Esta incisura es una característica anatómica donde se produce una depresión o muesca, y en este caso específico, es el sitio donde los vasos mesentéricos superiores atraviesan la estructura. La presencia de esta incisura no solo delimita el extremo inferior del cuello sino que también marca el punto donde los vasos sanguíneos, como las arterias y venas mesentéricas superiores, tienen su paso a través del tejido pancreático.
.
Cuerpo
El cuerpo del páncreas se aleja de la cabeza, dirigiéndose hacia la izquierda y hacia arriba. En un corte sagital paramediano, presenta la forma de un prisma con tres caras: anterior, posterior e inferior.
Cola
La cola es la extremidad izquierda del páncreas, que se extiende desde el cuerpo y se afina formando una lámina hacia adelante, apuntando hacia el hilio del bazo.

Variaciones
El páncreas, aunque generalmente sigue una configuración anatómica estándar, puede presentar variaciones en su estructura que son importantes de comprender. Algunas de estas variaciones incluyen:
- Páncreas Anular:
- En ocasiones, se puede observar un páncreas anular, que se caracteriza por rodear completamente la porción descendente del duodeno a la altura de la ampolla hepatopancreática.
- Esta variante implica que el tejido pancreático forma un anillo alrededor del duodeno, lo que puede tener implicaciones en la función y la anatomía circundante.
- Páncreas Dividido:
- Otra variación posible es el páncreas dividido, que conserva su disposición embrionaria original.
- En este caso, los conductos excretores del páncreas permanecen separados en cada porción del órgano. Esta disposición puede tener implicaciones en la liberación de enzimas digestivas y la función del páncreas como un todo.
- Islotes Pancreáticos Aberrantes:
- También se pueden encontrar islotes pancreáticos aberrantes, que son áreas de tejido pancreático que están ubicadas de manera anormal en los mesos circundantes.
- Estos islotes pueden encontrarse fuera de la ubicación típica del páncreas y pueden afectar la función endocrina del órgano, ya que los islotes son responsables de la producción y liberación de hormonas como la insulina y el glucagón.
Estas variaciones anatómicas del páncreas son importantes de reconocer, ya que pueden tener implicaciones en la función del órgano y en la relación con estructuras circundantes. Comprender estas variantes es esencial en contextos clínicos, como en la interpretación de estudios de imagen o en intervenciones quirúrgicas, donde el conocimiento detallado de la anatomía es crucial.